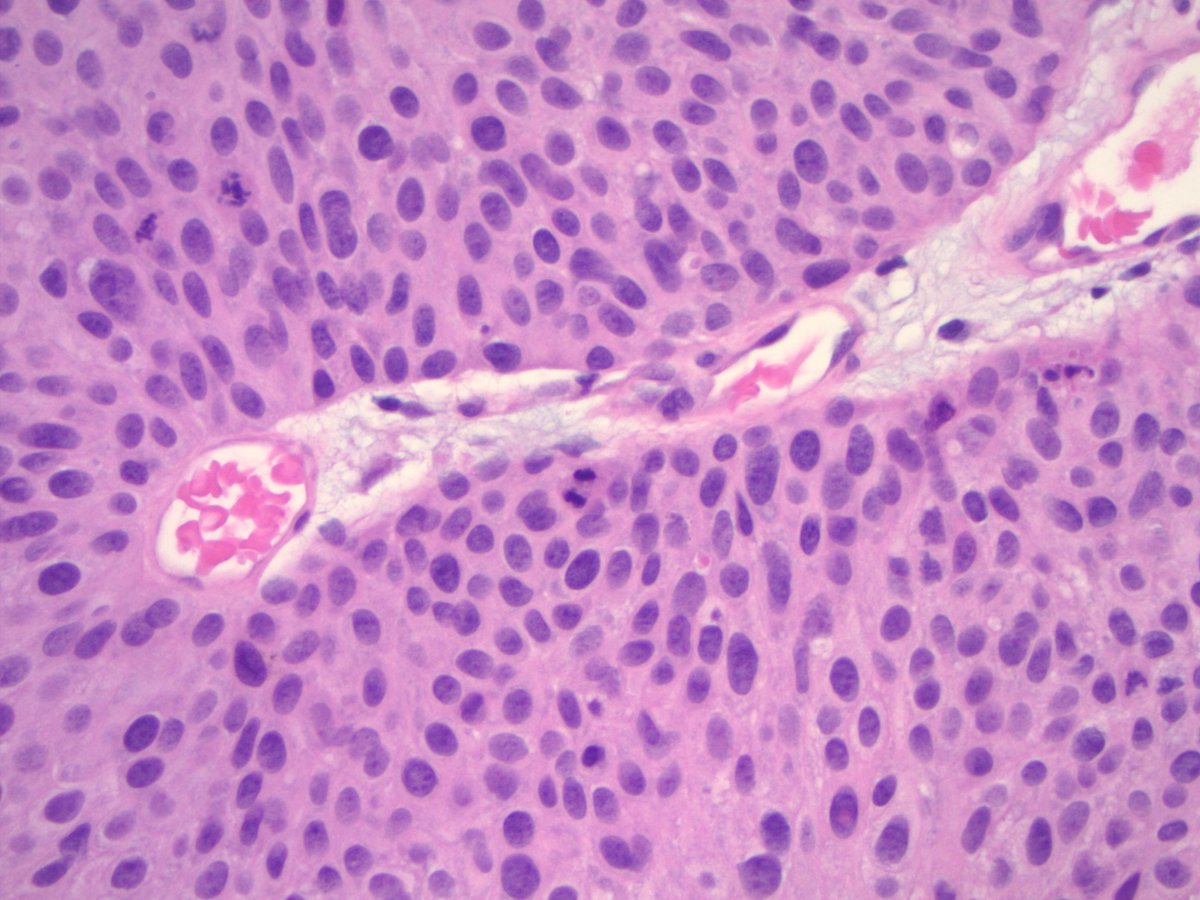
riham_katkhuda's tweet image. ALL are High grade papillary urothelial carcinoma, EXCEPT one Low grade, could you recognize it ?
#path2path #PathTwitter #GUpath #gupath

#path2path search results
Hi! I am Somayeh, an Iranian pathologist, As I applied to the #PathMatch2026, Looking forward to connect with peers & mentors. #Path2Path #Match2026 #Pathtwitter 🌟AAMC ID: 16429027 🌟 Any advice is welcome and appreciated.

A finding in a D&C specimen from a missed abortion. X4 and X10 Diagnosis? #Pathology #Pathresidents #Path2Path #Pathmatch25 #Pathmatch26 #OBGYNPath


What can you tell me about the patient? Obviously, have to figure out what it is, first. #PediPath #PathTwitter #Path2Path #PathMatch26 X4, X10, X10, X20




Incredibly honored and excited to find out that I Matched into a Pathology Residency!! Anxiously awaiting Friday to find out where I will complete my residency training 🥹🎊 #Match2024 #Path2Path #PathMatch #NYITCOM #DOGreatThings

THIS IS SURREAL!!!! I matched to Mass General Brigham Pathology!!! Can’t wait to start this amazing adventure with this great group of people!!! 🥹😄🥳🍾 @BWHPath @MGHPathology #Match2024 #PathTwitter #path2path


Don’t forget to apply for our Global Observership program! #PathMatch26 #Path2path #PathTwitter dlmp.uw.edu/education/glob…

A ✨star-studded✨ cast of Pathology residency open houses coming up this week. RSVP and save the date! Full event details and link can be found in the link in our bio. @MatchToPath @Inside_TheMatch #pathology #Path2Path #PathX #PathTwitter #Match2025 #PathMatch25 #pathmatch

Excited to push some glass or.. in the future, move a cursor xD #pathmatch2025 #PathMatch25 #Path2Path

Excited to join the best kept secret in medicine! Shoutout to the mentors who have helped me along the way @KMirza #loading #pathmatch2024 #path2path #Match2024

Hi #PathTwitter I’m Nikki, from Los Angeles. I love cats, archery, video games, hiking/climbing, and collecting more books than I could ever possibly read. I am very excited to finally be participating in #PathMatch24 #path2path #Match2024

Uchicago pathology department👩⚕️🧑⚕️🥼🥇🎯💪🩸🔬🦠🧬 #Match2024 #PathMatch #Path2path #Pathmatch2024 #PathTwitter #Uchicago


A 30 Yr | 👩 🎯 SiTe: Recto-Sigmoid 🔪CuT: A 6x3cm punched out Ulcerating Mass with raised borders 🔬DiAgNoSis? #Pathresidents #Pathology #Path2Path #PathTwitter #GIpath @Pathologists #pathx

Posting a few days late, but @UTMB_Pathology residents have now hit 34 publications for 2023; we've run out of room on our publication board! 26 more days to hit our goal of 36 pubs for the year; LET'S GO! #UTMBSIR #Path2Path #PathMatch24 #PathMatch2024 #PathTwitter

ALL are High grade papillary urothelial carcinoma, EXCEPT one Low grade, could you recognize it ? #path2path #PathTwitter #GUpath #gupath

#USCAP2025 here I come! So glad that our poster got accepted for the annual meeting! #PathMatch2024 #Path2Path #PathTwitter #pathX @PathatUCD

Joining @UMass as a #Pathology resident inshAllah! ✨ #Match2023 #Path2path #PathMatch2023 @UMassChan #Alhamdullilah

A 15 Yr | 👧 🦋THYROID |● Well-Capsulated, 5x3x2cm, Dark Brown Mass with Tiny Cystic Lacunae 🧇 filled with Blood. ➴CaN yoU DiAgNOsE iT? #Pathresidents #Pathology #Path2Path #PathTwitter #Endocrinepath @Pathologists

🎙️ Join us for Grand Rounds on Fri 11/14 at 8:00 AM PT featuring Dr. Amy Chadburn presenting on "HIV-Related Lymphomas, Lymphoproliferative Lesions and Lymphoid Hyperplasias, and Castleman Disease." Full schedule here ➨ bit.ly/3BMx0E3 #Pathology #Path2Path #PathX…

🔬🇺🇸 In honor of Veterans Day, we are celebrating our Department Veterans! Dr. Gregory Gates served in the US Navy for 14 years with 4 years in Pathology Residency and 4 years as a General Surgical Pathologist. Thank you for your service, Dr. Gates! #pathology #path2path #PathX…

🔬🇺🇸 In honor of Veterans Day, we are celebrating our Department Veterans! Dr. Ryan Austin served in the US Navy for 12 years as a Flight Surgeon and Pathologist. Thank you for your service, Dr. Austin! #pathology #path2path #PathX #VeteransDay

🏅 Congratulations to Dr. Andrea McGonigle and Dr. Cindy Tay on receiving a Translational Research Fund Grant for their project "Selective Blood Donor Testing for a Sickle Cell Standing Donor Pool." #pathology #path2path #PathX #research #transfusionmedicine


💫 We invite you to read & reflect on Dr. Sarah Dry’s November Chair Message. It features Division updates along with department events and news. #pathology #path2path #PathX Read More ➨ bit.ly/47Eg6r4




What can you tell me about the patient? Obviously, have to figure out what it is, first. #PediPath #PathTwitter #Path2Path #PathMatch26 X4, X10, X10, X20




📽️✨An inside look at life in the UCLA Pathology Residency Program! We’re excited to share the moments that shape our residents - from the microscope to mentorship, and everything in between. Watch the full video ➨ youtu.be/Yfw39_U9_Hg #pathology #path2path #PathX…

youtube.com
YouTube
UCLA Pathology & Laboratory Medicine Residency Program
🎙️ Join us for Grand Rounds on Fri 10/24 at 8:00 AM PT featuring Dr. Dan Milner (@damilnermd) presenting on "Pathology Capacity in Global Health." Full schedule here ➨ bit.ly/3BMx0E3 #Pathology #Path2Path #PathX #ClinMicro

Don’t forget to apply for our Global Observership program! #PathMatch26 #Path2path #PathTwitter dlmp.uw.edu/education/glob…

🔬UCLA Pathology's Post-Sophomore/Junior Fellowship Program is now recruiting medical students to join our 1-Year #Pathology Fellowship for 2026-2027! Apply today! 👉 bit.ly/4mexWqi #PathX #path2path #pathfellowship @Path_SIG @PathElective @Inside_TheMatch @dgsomucla
What’s due tomorrow, Oct 15?🤔 – The start of the bulky residency interview invitation release…🔬 – And the deadline❗️to submit my two posters and one oral presentation for ASDP 62nd. Wishing the best of luck to all of us 🍀 #Match2026 #MatchToPath #Path2Path #IMGPathologist



A finding in a D&C specimen from a missed abortion. X4 and X10 Diagnosis? #Pathology #Pathresidents #Path2Path #Pathmatch25 #Pathmatch26 #OBGYNPath


What can you tell me about the patient? Obviously, have to figure out what it is, first. #PediPath #PathTwitter #Path2Path #PathMatch26 X4, X10, X10, X20




Hi! I am Somayeh, an Iranian pathologist, As I applied to the #PathMatch2026, Looking forward to connect with peers & mentors. #Path2Path #Match2026 #Pathtwitter 🌟AAMC ID: 16429027 🌟 Any advice is welcome and appreciated.

A ✨star-studded✨ cast of Pathology residency open houses coming up this week. RSVP and save the date! Full event details and link can be found in the link in our bio. @MatchToPath @Inside_TheMatch #pathology #Path2Path #PathX #PathTwitter #Match2025 #PathMatch25 #pathmatch

Done with my last interview! Happy that I got to meet and talk to amazing pathologists,residents and program coordinators along the way! Path community is amazing!!!! 🔬😍#PathMatch2023 #PathTwitter #Path2Path

THIS IS SURREAL!!!! I matched to Mass General Brigham Pathology!!! Can’t wait to start this amazing adventure with this great group of people!!! 🥹😄🥳🍾 @BWHPath @MGHPathology #Match2024 #PathTwitter #path2path


Prospective pathology residents. Save the date for our upcoming Virtual Meet & Greet sessions! @UCLA_Pathology . #pathmatch #path2path #pathtwitter Please register here: uclahs.az1.qualtrics.com/jfe/form/SV_bj…

Incredibly honored and excited to find out that I Matched into a Pathology Residency!! Anxiously awaiting Friday to find out where I will complete my residency training 🥹🎊 #Match2024 #Path2Path #PathMatch #NYITCOM #DOGreatThings

Please join us for "To Lump or to Split? Emerging Entities in Soft Tissue #Pathology," @WCMCPathology #GrandRounds by Dr. David Papke (@PapkeDavid) from @harvardmed @BWHPath! @pathologysocial #path2path @Path_SIG #LabMedicine Come for the science (🧪), stay for the pizza (🍕)!

Hi #PathTwitter! I'm Abdalla from🇪🇬, I am excited to share I'm applying #PathMatch2025. A proud HemePath, GI, and DermPath enjoyer. I'm also a chess obsessed nerd♟️Excited to connect with mentors and the amazing pathology community as I make this next move!🔬#Path2Path #pathX

Why choose submitting your article to us! We won’t disappoint you! #cytopath #path2path #pathmatch24 #globalpath cc: @aakasharmand

Today is the day! @UABPathology is thrilled to announce and welcome our incoming residents! Thank you for an incredible #PathMatch24. We look forward to welcoming these individuals into the UAB Pathology family! #Match24 #path2path

#CAP23 made it possible to get to meet the awesome community of supportive residents #Path2Path #PathX



Posting a few days late, but @UTMB_Pathology residents have now hit 34 publications for 2023; we've run out of room on our publication board! 26 more days to hit our goal of 36 pubs for the year; LET'S GO! #UTMBSIR #Path2Path #PathMatch24 #PathMatch2024 #PathTwitter

Something went wrong.
Something went wrong.
United States Trends
- 1. Comey 124K posts
- 2. GeForce Season 1,641 posts
- 3. Everton 78K posts
- 4. Dorgu 10.2K posts
- 5. Gueye 17.4K posts
- 6. Opus 4.5 5,396 posts
- 7. Mark Kelly 85.7K posts
- 8. Keane 11.5K posts
- 9. Seton Hall N/A
- 10. Halligan 39.6K posts
- 11. #MUNEVE 8,475 posts
- 12. Department of War 24.7K posts
- 13. Hegseth 31K posts
- 14. Amorim 26.4K posts
- 15. Pentagon 17.9K posts
- 16. #WooSoxWishList 12K posts
- 17. UCMJ 12.8K posts
- 18. Zirkzee 13.2K posts
- 19. Gana 55.5K posts
- 20. Creighton 1,983 posts









































